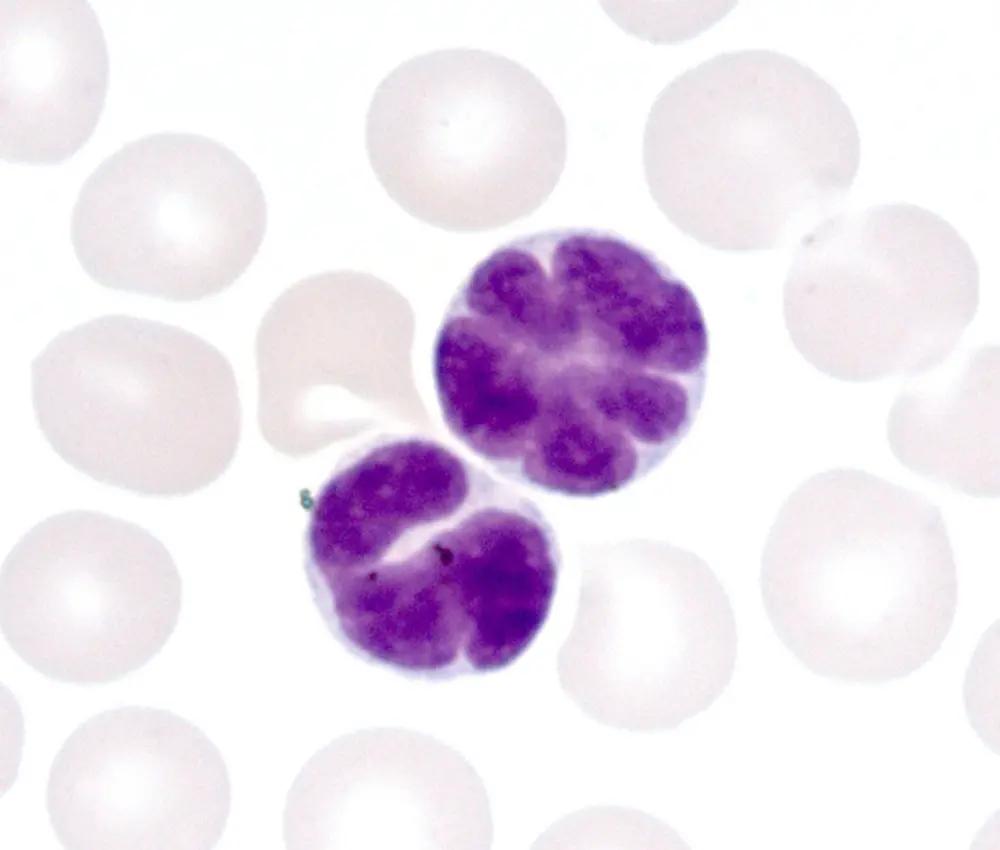
末梢血中のATL細胞

血液内科
当科では、白血病、悪性リンパ腫、多発性骨髄腫などの造血器腫瘍を中心に、貧血や血小板減少などの良性疾患まで、血液疾患全般にわたる専門的な診療を行います。
血液疾患は診断が複雑で、治療が長期にわたることも少なくありません。私たちは、最新の科学的根拠(エビデンス)に基づいた標準的治療を軸に、患者さんお一人おひとりの病態や生活環境に合わせた最適な治療方針を丁寧にご説明し、納得して治療を受けていただけるよう努めています。松岡医師は元・熊本大学病院・血液内科教授であり、最先端の治療をお届けします。
- 主な診療対象疾患
-
- 急性・慢性白血病
- 成人T細胞白血病
- 悪性リンパ腫
- 多発性骨髄腫
- 骨髄異形成症候群(MDS)
- 再生不良性貧血、特発性血小板減少性紫斑病(ITP)などの良性疾患
スタッフ紹介
-
松岡 雅雄
院長
- 資格・認定
- 日本学術会議連携会員、難病指定医、緩和ケア研修会修了
-
村田 克美
血液内科副部長
- 資格・認定
- 緩和ケア研修会修了
-
三井 士和
血液内科医師(非常勤)
- 資格・認定
- 血液専門医、がん薬物療法専門医・指導医、日本内科学会・認定内科医・総合内科専門医
-
井上 明威
血液内科医師(非常勤)
- 資格・認定
- 熊本大学病院血液内科 特任助教、血液専門医・指導医、総合内科専門医、日本内科学会・認定内科医・総合内科専門医、輸血・細胞治療学会認定医、造血・免疫細胞治療学会・造血細胞移植認定医
治療の一例
成人T細胞白血病/リンパ腫(ATL)はヒトT細胞白血病ウイルス1型(HTLV-1)の感染によって引き起こされる病気です。HTLV-1感染者は南九州に多く、八代地域にも多いことが知られています。感染者の殆どは問題ありませんが、一部の感染者がATLを発症します。以前は治療法が少なく予後が悪い疾患でしたが、近年、新たな治療法が開発され予後は改善しています。松岡はHTLV-1による発がん機構を明らかにし、治療法の開発にも積極的に取り組みました。